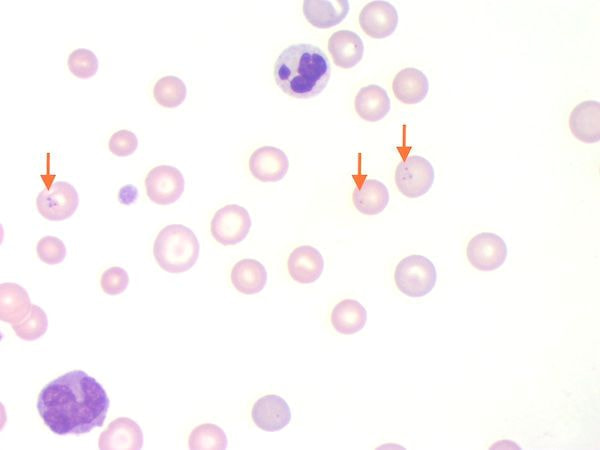
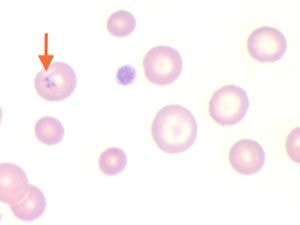
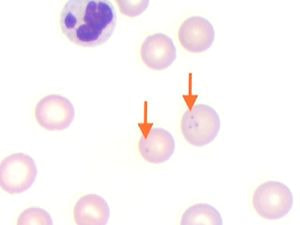

診療時間
HOURS
休診日は木曜日
日曜・祝日は午前診療

☆日曜日:完全予約診療(祝日:予約不要)
★平日お昼の時間帯(11:30~15:30)ならびに火曜午後は、手術や予約制の特殊検査の時間となります
休診日は木曜日
日曜・祝日は午前診療となります
診察時間 | 月 | 火 | 水 | 木 | 金 | 土 | 日/祝 |
---|---|---|---|---|---|---|---|
9:00-11:30 | ○ | ○ | ○ | 休 | ○ | ○ | ☆/○ |
15:30-19:00* | ○ | ★ | ○ | 休 | ○ | ○ | 休 |
☆日曜日:完全予約診療(祝日:予約不要)
★平日お昼の時間帯(11:30~15:30)ならびに火曜午後は、手術や予約制の特殊検査の時間となります
診療案内
INFORMATION
健康診断(DogDoc&CatDoc)のご案内
当院では、7歳以上のわんちゃん、ねこちゃんに健康診断をお勧めしています。
その一方で高齢化に伴い腫瘍性疾患や心臓病、腎臓病などの高齢期に特有の病気が増加傾向にあります。
これらの病気は早期発見が病気克服のために非常に大切ですが、犬や猫は自分で言葉を発することが出来ないため、体の調子が悪くても飼主に訴えることが出来ません。
当院に連れてこられる患者さんの中にも、もっと早くに気付いてあげられたら・・・と考えてしまう病気のこたちがたくさんいます。
話すことが出来ない動物たちにかわって異常にいち早く気付いてあげられれば、病気の治療方法や予後も大きく変わる可能性があります。
この健康診断がその一助になってくれればと思っています。

もちろん7歳未満のわんちゃん、ねこちゃんでもOKです。
若く元気な頃の検査データがあれば、年を重ねてからの推移も見ることができます。
検査は一般の外来時間とは分けてお昼の時間帯に行います。
なお、検査当日は 朝ご飯抜き で来院してもらいますのでご注意ください。
検査結果のお話は、後日改めて時間をとってご説明します。
(緊急性のある疾患が見つかった場合は検査当日のうちにお話しさせて頂きます)
DogDoc&CatDocは 完全予約制 になっていますので、ご希望の方はお電話でご予約下さい。
ご不明な点などありましたら、お気軽に当院までお問い合わせ下さい。
検査内容
・身体検査・・・・・・視診、聴診、触診
・尿検査・・・・・・・糖尿病、腎臓病、肝臓病、尿路結石症など
・糞便検査・・・・・・寄生虫の有無など
・眼科検査・・・・・・視覚反応、白内障の有無、眼圧、網膜の異常など
・血液一般検査・・・・炎症反応、貧血、血小板の異常など
・血液生化学検査・・・肝臓病、腎臓病、糖尿病、高脂血症の有無など
・頭部・胸部・腹部レントゲン検査
追加検査(上記検査結果をふまえ、ご希望により追加可能です)
・胸部エコー検査・・・弁膜症、心筋症、先天性心疾患の有無など
・腹部エコー検査・・・腹腔内の腫瘍性疾患の有無など
・眼内エコー検査・・・眼内の異常、網膜剥離など
・血液内分泌検査・・・甲状腺機能亢進症/低下症、副腎皮質機能亢進症など
・血液凝固系検査・・・血液凝固異常の有無、DICの判定など
検査料金(税抜き)
・猫&小型犬(10kg未満)
・・・・・16,000円
・中型犬(10kg以上20kg未満)
・・・・・19,000円
・大型犬(20kg以上)
・・・・・22,000円
(追加のエコー検査、血液内分泌検査、凝固系検査は別料金になります)
<検査結果見本>
心臓検査(心臓Doc)のご案内
心臓の検査に重点をおいた心臓ドックも実施しています。
いずれの場合も、初期の段階では症状に気付かないことも多く、身体検査で初めて心臓病の存在が疑われることがありますので、下記のような症状が認められる場合には一度検査を受けられることをお勧めします。

・散歩に行くのを嫌がるようになった
・ちょっと運動しただけで疲れてしまう
・いつも寝てばかりいる
・すぐに呼吸が荒くなり、舌の色が紫色になる
・興奮時に咳をする
・ふらついたり、失神したことがある
・お腹が膨らんできた
・兄弟犬に比べて発育が遅く、体つきが小さい
・開口呼吸をしている(猫)
・瞳孔が開いており、物があまり見えていない様子(とくに猫)
・後ろ足の動きがおかしい(とくに猫)
これらの症状は心臓病の重要なサインのことがあります。心臓病の多くは進行性であることが多く、早期発見・治療が予後に大きく影響します。心臓検査には聴診などの身体検査のほか、血圧測定、心電図検査、胸部レントゲン検査、心臓超音波検査、血液検査(心臓病のマーカーであるANPやNT-proBNPの測定)など様々な検査があり、これらの検査を症状に応じて組み合わせて実施し総合的に診断していきます。
心臓ドックは、別途ご案内のDogDocやCatDocと同様に、 お昼の時間帯に予約制で実施しております。
検査をご希望の方は事前にお電話でご予約下さい。
心臓ドック検査内容
・血圧測定
・心電図検査(ホルター心電図は必要に応じて実施 *下記参照)
・胸部レントゲン検査
・心臓超音波検査
・血液検査(ANP、NT-proBNP等の血液検査は必要に応じて実施)






測定中は自宅で普段通りの生活をして頂き、失神やふらつきが起こった場合はその時間を記録して頂きます。
3日間測定した後ホルター心電図を回収し、症状発現と同時刻に不整脈があったかどうか解析します。
検査料金(税抜き)
・猫&小型犬(10kg未満)
・・・・・10,000円
・中型犬(10kg以上20kg未満)
・・・・・12,000円
・大型犬(20kg以上)
・・・・・14,000円
(ホルター心電図、ANPおよびNT-proBNPの測定は別料金になります)
<検査結果見本>
代表的な心臓病に関しては、別ページでもご紹介していますのでご覧ください。
フィラリア予防と検査について

蚊が吸血する際に、蚊の体内にいたフィラリアの幼虫が動物に感染します。感染したフィラリア幼虫は動物の体内を移動しながら成長し、最終的には血流にのって心臓から肺動脈にたどり着きます。肺動脈に寄生したフィラリア幼虫は感染から6ヶ月程で成虫になり、子虫(ミクロフィラリアといいます)を産み始めます。
フィラリアの成虫はそうめん程の太さで体長は15~30cmにもなりますので、 感染犬は咳や運動不耐性(疲れやすい)、腹水の貯留など様々な呼吸器症状と右心不全症状を示し、最終的には死に至ります。
猫は犬に比べフィラリアに抵抗性を持っていますが、室内飼いの猫でも感染例が報告されており、 嘔吐や咳、呼吸困難などの呼吸器症状や突然死の原因 となります。



フィラリア予防の仕組み
フィラリアの予防薬は、犬や猫の体内に侵入したフィラリアの幼虫を駆除するお薬です。体内に侵入したフィラリア幼虫は、動物の皮下や筋肉内に約1ヶ月とどまっていますので、この期間に予防薬を服用し駆除していきます。このためフィラリア予防薬の投薬期間は「感染期間開始1ヵ月後から感染期間終了1ヵ月後まで」となります。この感染期間はその年の気温によって変動します。蚊の体内でフィラリア幼虫が成長し、動物への感染能力を持つようになるには暖かい気温が必要だからです(寒いとフィラリアは成長できず動物に感染することができません)。
これまでは、松山市におけるフィラリアの感染期間は概ね5月上旬〜11月上旬までとなっていましたので、投薬期間は6月上旬〜12月上旬までになります。しかし近年の温暖化により、フィラリアの感染開始時期が早まってきていることが懸念されています。従来は6月上旬からフィラリア予防を開始していましたが、近年は5月上旬の予防開始をお勧めしています。
(投薬期間:5月上旬〜12月上旬 計8回服用)
フィラリア検査の必要性
当院では毎年4月上旬から5月上旬にフィラリア検査を実施しています。投薬前の時点でフィラリアの成虫に感染していないかどうかを調べるための、血液中のフィラリア抗原検査です(幼虫の段階では検査で検出することはできません)。万が一、心臓や肺動脈に成虫が感染していることを知らずにフィラリア予防薬を飲ませると重篤な副作用が出る場合がありますので、事前に検査を受けられることをお薦めします。とくに前年にお薬の飲ませ忘れがある場合は、必ず投薬前にフィラリア検査を受けてください。
(猫のフィラリア検査は検出率が低いため、感染の疑いが強い時のみ実施します)
予防薬は、チュアブル(お肉タイプ)、錠剤、粉薬、スポット(背中に滴下するタイプ)をご用意しています。
(猫はスポットタイプになります)
お腹の虫を一緒に駆虫できるものやノミ予防を兼ねているもの等、それぞれ特徴がありますので詳しくは当院までご相談ください。
マダニ予防と注意点
春から秋にかけて、お散歩中に注意しなければならない寄生虫の1つが「マダニ」です。
マダニは木や草の葉先にひそんでおり、犬や猫が近くを歩いたときに体に付着します。都会でも公園や道路沿い植え込み、芝生などから動物にうつることがあります。

動物の被毛に付着したマダニは、目の周りや耳の付け根、頬などの皮膚のやわらかいところに移動し吸血します。
吸血前のマダニは2~3mm程度の大きさですが、吸血すると何十倍にも大きく膨らみ小豆大くらいになります。通常は2~3匹の寄生ですが、ときには数十匹~数百匹も寄生していることがあります。
マダニは専用のピンセットを用いて慎重に除去します。吸血中のマダニはノコギリのような口先とセメントのような物質を分泌して皮膚にしっかりと咬み付いているため、引っ張ってもなかなか取れません。 無理にひっぱると口先がちぎれて皮膚の中に残ってしまうことがあるほか、 誤ってつぶしてしまうとダニの体内に含まれる有害な物質が出てきて危険です。ご家庭で無理に取ろうとせず必ず動物病院で診てもらって下さい。
重症熱性血小板減少症候群(SFTS)に要注意!
近年、マダニが人に「重症熱性血小板減少症候群(SFTS)」のウイルスを媒介すると話題になっていますが、犬や猫でも発熱や食欲廃絶、黄疸、白血球減少や血小板減少などの重篤な症状を示し死亡した事例が報告されています。さらにSFTSを発症した犬や猫から人へ感染することもわかってきました。人と同様に、動物も発症すると致死率が高く非常に恐い病気ですので、マダニ予防が極めて大切になります。
(厚生労働省HP 「重症熱性血小板減少症候群について」)
バベシア症について
SFTS以外にもマダニの吸血によって感染してしまう病気がいくつかあり、その代表的なものが「バベシア症」です。バベシアはマダニが吸血する際に犬の血管内に侵入する原虫で、犬の赤血球内に寄生したのち赤血球を破壊します(溶血)。バベシア症は一度感染してしまうと完治が難しく、「溶血性貧血」により命に関わることもある恐い病気です。

お散歩コースが山道や河原など、草むらをよく通る場合はマダニの予防をしてあげましょう。とくに外飼いのわんちゃんや、お外へ自由に出入りしているねこちゃんは公衆衛生上の観点からも予防することをお勧めします。
背中に滴下するスポットタイプのほか、頻繁にシャンプーや水遊びをするわんちゃんには飲み薬タイプもおすすめです。効果は1ヶ月程持続するものが多いですが、最近では3ヶ月持続する飲み薬タイプもあります。
またマダニだけでなく、ノミの駆虫を兼ねてる製品が多いのでノミ予防にもなります。
お薬の飲ませ方や投与方法など、詳しくは当院までご相談ください。
ノミの生態とノミ媒介性疾患
マダニとならんで犬、猫に寄生する代表的な寄生虫が「ノミ」です。
体長は1~2mmほどでとても小さく動きも速いため、マダニと違って見つけにくいのが難点です。

ノミは梅雨の前後から活発に発生し増殖しますが、暖かい住宅の中ではほぼ一年中生存可能と言われています。
犬や猫に寄生したノミは、被毛の中に潜り込んですぐに吸血を開始し卵を産み始めます。ノミ1匹につき1日に30個以上も産卵し、卵は動物の体表から落下した後、数日で孵化して幼虫になります。幼虫は順調に成長すると1ヶ月程で蛹から成虫となり、再び動物に寄生します。
こうしてノミは次々に産まれ驚異的な繁殖力で増えていきます。
ノミ媒介性疾患について
犬や猫がノミに刺されると激しい痒みに襲われるだけでなく、吸血が繰り返されると動物がアレルギー状態となり、背中から腰にかけて皮膚炎が拡がることがあります「ノミアレルギー性皮膚炎」。一度ノミアレルギーになると、その後のノミの寄生がたとえ少数であっても、激しい痒みや湿疹、脱毛などがおこります。

また、ノミの体内に瓜実条虫(サナダムシの仲間)の幼虫が潜んでいることがあり、犬や猫がグルーミングなどでノミを食べてしまうと、瓜実条虫がノミの体内から出てきてそのまま犬・猫の小腸に寄生し、下痢や嘔吐の原因になります。
その他にも、猫に貧血を引き起こす「猫ヘモバルトネラ症」や、猫にひっかかれて人に感染する「猫ひっかき病」など、ノミが媒介する病気は意外と多いのです。
これらノミ媒介性疾患は、適切なノミ予防薬を使用することにより未然に防ぐことが出来ます。
背中に滴下するスポットタイプのほか、最近では飲み薬タイプもあります。
マダニの駆虫を兼ねている製品が多いなか、フィラリア予防が出来るもの、お腹の中の寄生虫(回虫、条虫など)や耳ダニを駆除出来る製品もあります。
それぞれに特徴がありますので、詳しくは当院までご相談ください。
ワクチン接種とその種類
当院で扱っている混合ワクチン
飼育環境によって必要なワクチンは異なりますので、ご相談の上接種するワクチン種類を決めます。

混合ワクチンの重要性と副作用
ワクチンとは、感染症のウイルスや細菌の毒素を弱めた「抗原」のことです。
ワクチン(抗原)を注射することにより、この「抗原」に対抗する「抗体」が体内で新たにつくられます。
この抗体により、次に体内に侵入しようとする病原体から自身を守るのです。
病気予防の観点から考えると、ワクチン接種は大変重要なものといえますが、まれにワクチン接種による副作用でアレルギー反応が出る場合があります。
以下に代表的な副作用について記します。

①アナフィラキシーショック:虚脱(ぐったりする)、意識・体温の低下→1時間以内
②アレルギー様症状:じん麻疹・顔が腫れる・掻痒(かゆみ) →10時間以内
③発熱、嘔吐、下痢、食欲・元気減退→1〜3日
④接種部位の腫脹・硬結・疼痛→2、3日〜1週間
(発症時期はおおまかな目安で個々の反応により異なります)
最もよく見られる副作用は②のアレルギー様症状で、顔がむくんだように腫れてひどく痒がります。 (まれに顔以外にもじん麻疹や痒みが出る場合があります)
この反応は数時間経ってから出る場合が多く、夕方にワクチンを接種すると真夜中にアレルギー反応が出る場合がありますので、ご自宅で様子を見ていられる日の午前中の接種をおすすめします。
とくにまだ体力のない子犬や子猫、高齢のわんちゃん、ねこちゃんの場合は必ず午前中に来院して下さい。
過去にアレルギー反応がでたことのある場合は事前に受付までお伝えください。
(ワクチン接種前にアレルギー反応をおさえる注射をする場合があります)
雌の場合、生理中は体調をくずしやすいためワクチン接種はなるべく避けて下さい。
また妊娠中はワクチンは打てませんのでご注意ください。
子犬・子猫の混合ワクチン接種の時期と回数
産まれたばかりの子犬や子猫は、生後母乳によって病気に対する抗体を母親から受け継ぎます。
これを移行抗体といいますが、この移行抗体は子犬の場合、生後約6週くらいから徐々に減少していきます。以降は自分で抗体を作らなければいけません。
そこで、移行抗体が消滅しかけた時期にワクチンを接種しますが、消滅する時期については個体によってさまざまで予測することは不可能です。
一般に子犬の場合、生後約7〜8週で1回目の接種を行っていますが、移行抗体が残っている場合はワクチンの効果が得られませんので、3週間〜1ヶ月おきに計3回のワクチン接種を行います。以後は1年後の接種となります。
子猫の場合は、生後約8〜9週に1回目、3週〜1ヶ月後に2回目の接種を行い、その後は1年後の接種となります。
もちろん子犬、子猫を飼い始めた時期により上記の通りに打てない場合もあります。
生活環境(多頭飼いの場合など)や各々の体格、成長具合を考慮して最終的にワクチン時期を決定します。
初年度ワクチン時の便検査の必要性
子犬・子猫の場合、ワクチン接種時に便検査を実施しますので、当日の朝の便をお持ちください。
お腹の中に寄生虫がいないか調べるための検査で、寄生虫がいる場合は症状により先に駆虫が必要となる場合があります。
(検査を重ねることにより精度が増しますので初年度は毎回便をお持ちください)
子犬のワクチン接種後の散歩
2回目のワクチンを接種して、2週間後には抱っこしてのお散歩に連れ出してもかまいません。ただし地面におろしての本格的なお散歩や、ワクチン未接種のわんちゃんとの接触、トリミング、ペットホテル等は最後のワクチンが終了し2週間経過するまで待って下さい。
ワクチン接種済みのわんちゃんとであれば2回目接種後から遊ばせてあげてもかまいません。
この時期は社会化期といって、いろいろな刺激を受け環境に慣れさせる大事な時期でもあります。
あまり過保護にしすぎると散歩を怖がるようになったり、他の犬とコミュニケーションをとるのが苦手になる場合があります。
狂犬病ワクチン
狂犬病ワクチンは上記の混合ワクチンとは異なります。
生後91日齢を過ぎたら年に1回、毎年接種するよう狂犬病予防法で義務づけられています。
(厚生労働省HP 「狂犬病について」)
子犬の場合、混合ワクチンとの兼ね合いもありますので、接種時期についてはご相談ください。
犬、猫の避妊手術について
将来、繁殖を予定している犬・猫でなければ、なるべく早期の避妊手術をお勧めします。
早期の避妊手術を勧める最大の理由は乳腺腫瘍の発生率と関係があります。
乳腺腫瘍は、乳腺に様々な大きさの“しこり”ができる病気です。
雌犬にみられる腫瘍の中では最も多く、腫瘍性疾患の中で乳腺腫瘍の発生率は50%近くを占めます。
また、犬の乳腺腫瘍のうち「良性」と「悪性」の比率は半々といわれていますが、猫の場合、約80~90%は「悪性」です。
乳腺腫瘍の発生原因は不明ですが、雌性ホルモンとの関連性が極めて高いことがわかっており、早期に避妊手術をした雌犬は、乳腺腫瘍を発症するリスクが明らかに減少するという報告があります。
乳腺腫瘍の予防効果(犬)
・1回目の発情出血が始まる前に避妊手術を行った場合:99.5%
・2回目の発情出血が始まる前に避妊手術を行った場合:92%
・2回目の発情の後に避妊手術を行った場合:74%
・2歳半以上で避妊手術を行った場合:予防効果なし
猫の場合も同様の報告があります

・生後6ヶ月までに避妊手術を行った場合:91%
・生後7~12ヶ月までに避妊手術を行った場合:86%
・生後13~24ヶ月までに避妊手術を行った場合:11%
・24ヶ月以降に避妊手術を行った場合:予防効果なし
上記のように、犬、猫ともになるべく早期に避妊手術を実施するのが理想と言えますが、
個々の体格や成長具合に応じて手術時期を決定する必要があります。
(一般的には生後5〜6ヶ月で手術適期となります)
避妊手術は開腹して子宮と卵巣を摘出する方法をとりますので、子宮と卵巣の病気予防にもなります。手術後は傷口を舐めないようにエリザベスカラーを貸し出ししているほか、エリザベスウェア(術後服)も取り扱っております。
手術前には全身状態の把握、麻酔リスクの評価のための検査(血液検査、胸部レントゲン検査、心電図検査)が必要となります。
事前にご予約が必要ですので、詳しくは当院までご連絡ください。
去勢手術について
雄の場合も、病気予防という観点から去勢手術を行うことがあります。

・会陰ヘルニア
・前立腺肥大
・肛門周囲腺腫
・精巣の腫瘍
これらの病気は雌と異なり、いつまでに手術すれば予防になるといった報告はありませんが、年齢を重ねてからの手術よりも、若く元気なうちに手術したほうが麻酔の負担やリスクも少なくすみます。
体格や、精巣の状態にもよりますが、一般的には生後5ヶ月頃から手術可能となります。
また、胎生期にはお腹の中にある精巣(睾丸)が生後ゆっくりと下降し陰嚢のなかに収まりますが、
まれに下降しきれずにお腹の中に残ってしまうことがあります(停留睾丸、潜在精巣)
お腹の中の精巣は放っておくと腫瘍化する可能性があるため、なるべく早期の摘出手術が必要となります。
事前に超音波検査等で精巣を確認する必要がある他、通常の去勢手術の場合と同様に手術前の検査(血液検査、胸部レントゲン検査、心電図検査)が必要となります。
事前のご予約が必要ですので、詳しくは当院までお問い合わせください。